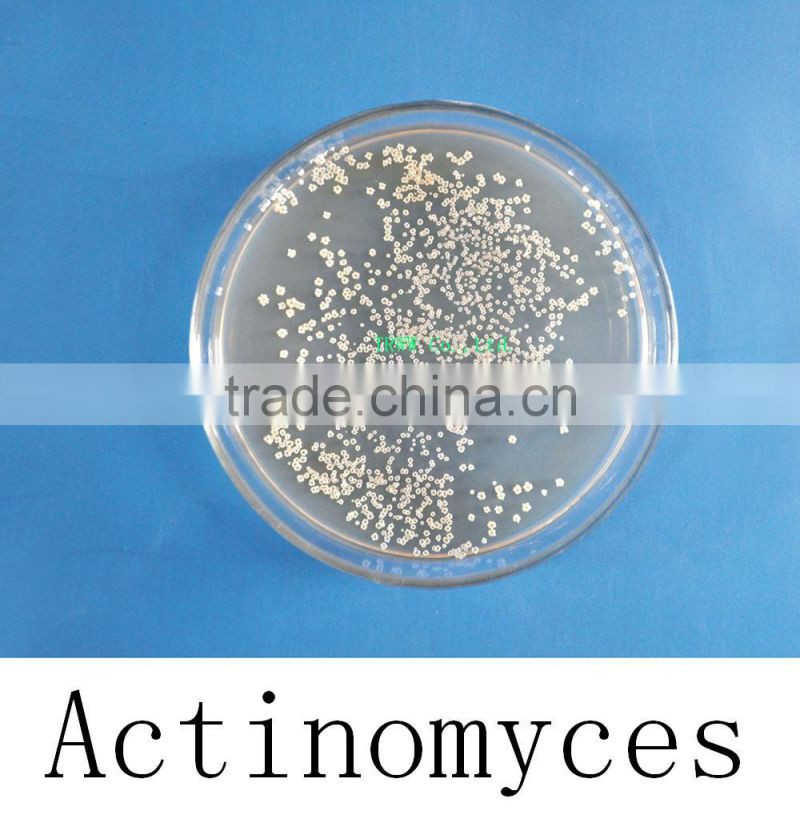
Actinomyces for agriculture planting

Welcome!



| Application | fermenting organic fertilizer | Brand Name | yongfa | Model Number | WF-YF017 |
|---|---|---|---|---|---|
| Place of Origin | Hebei, China | Purity | 90% | Release Type | Controlled |
| State | Powder | ||||
Actinomycete
[Main elements]: Actinomycete, ferment metabolites.
[Character]: Light yellow powder.
[Biological feature]: Actinomycete are a class group of prokaryotes. Most of them have developed branching hyphae. The hypha is thin, its wide is similar to the rod-shaped bacteria, about 0.5-1um.
They are named of actino-shaped group. They are one class group of prokaryotes, having a widely distribution in the nature, mainly reproduced as spore, some are fragmentation. The gram strain is positive.
Actinomycete distribute widely in the nature, mainly exist in soil, air and water as spore or hypha, especially, most of them exist in the neutral or alkalescent soil containing low water, rich organisms.
Most of the actinomycetes are aerobic, only some few kinds are aerobic bacteria and anerobic bacteria. So plenty of air should keep during the process of industrial ferment producing antibiotic; temperature is also influential to the growth of actinomycete, most of actinomycete’ best growing temperature is 23-37°C, thermoactinomycetaceae’s best growing temperature is in the range of 50-65°C, a lot of bacteria group can live well below the range of 20-23°C, actinomycete mycelium have more ability of drying resistance than vegetative bacteria, a lot of bacteria can live for about a year and a half in the desiccator of CaCl2 and H2SO4.
Principle: the main function of actinomycete is to absorb nutrient substances, most of them are heterotrophic ones except few are autotrophic bacteria like autotrophic streptomyces. The heterotrophic bacteria have great different request to nutrition, some can use simple compounds, but some require complicated organic compound. The best carbon source is glucose. About the nitrogen nutrition, the most suitable ones are protein and some amino acids, the more suitable are nitrate and ammonium salt.
[Main functions]: Actinomycete has intimate relations with the production and life of humans, now about 70 percent of the widely used antibiotics are generated by various actinomycetes. Some kinds of actinomycetes can generate different kinds of enzyme preparations (like protease, amylase, cellulase and etc.), vitamin B12, organic acid and etc.
[The quality index]:
The content of the living bacteria ( billion CFU per gram) | 10 20 |
The particle size of the product (mesh) | 60 to 100 |
The percent of moisture | Less than or equal to 10 |
[Using scope]: Steroidal transformation, hydrocarbon fermentation, oil dewaxing, the water adjusting of aquatic culturing and bottom improving, dealing with wastewater, agriculture, fertilizer, medicine and etc.
[Storage]: Keep it at a shady cool and dry place.
[Shelf life]: Eighteen months.
[Specification]: 25kg per bag.
Contact Us
Cangzhou Tianrunwanwu Biotechnology Co., Ltd.